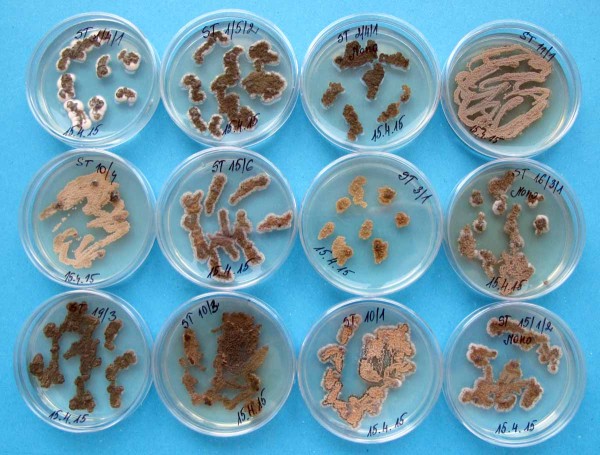
Zymoseptoria tritici (izol&aacute;ty na Petriho misk&aacute;ch), původce septoriov&eacute; skvrnitosti listů p&scaron;enice
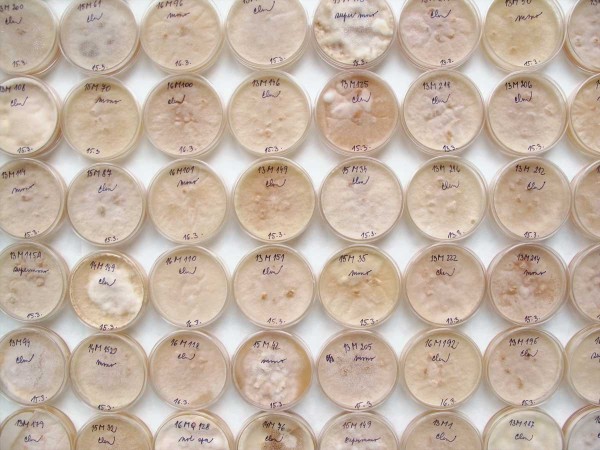
Microdochium spp. (izol&aacute;ty na Petriho misk&aacute;ch), původce sněžn&eacute; pl&iacute;sňovitosti obilnin
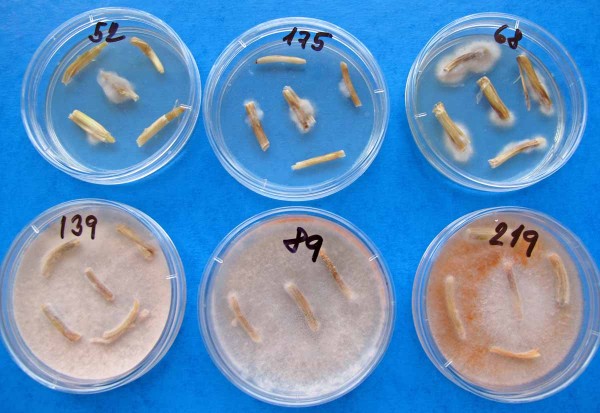
Oculimacula spp. (původce st&eacute;blolamu) a&nbsp;Microdochium spp. (původce sněžn&eacute; pl&iacute;sňovitosti) na Petriho misce

Důležitost plošného monitoringu nejen u rezistence
04. 07. 2019 Choroby Zobrazeno 877x
Rezistence škodlivých organizmů vůči pesticidům je závažným problémem celosvětově. Obzvláště významnými jsou případy vícenásobné rezistence vůči několika účinným látkám, jako například herbicidní rezistence metlice chundelky či psárky. Neméně závažná je situace u rezistence hmyzích škůdců vůči insekticidům, například blýskáčka řepkového nebo mandelinky bramborové, v neposlední řadě pak houbových patogenů vůči fungicidům.
Poslední zmíněné problematice se budeme věnovat v následujícím textu podrobněji, jelikož se monitoringem výskytu rezistence vybraných houbových patogenů obilnin vůči fungicidním látkám dlouhodobě zabýváme.
Význam monitoringu rezistence
Sledování aktuálního stavu a dynamiky rezistence v čase je možno považovat za jednu z důležitých strategií při zvládání rezistence v praktických podmínkách. Bez znalosti stavu a vývoje nelze aplikovat opatření vedoucí k oddálení vážných následků převládnutí rezistentních jedinců v populaci patogenů. Zvolili jsme pracnou a odborně i časově náročnou metodu pravidelného sběru vzorků a svozu do laboratoře, kde pomocí biotestu vyhodnocujeme úroveň rezistence kmenů hub vůči vybraným fungicidním látkám. Na základě zhodnocení rizik vzniku rezistence pro houbové choroby obilnin jsme se zaměřili na patogeny, u nichž je sledování rezistence vůči fungicidům dle našeho názoru nezbytné.
Zaměřili jsme se na ekonomicky nejzávažnější a široce zastoupené patogeny obilnin, jejichž výskyt je opakovaně plošně významný v dlouhé řadě let a u nichž v řadě případů není plně efektivní dědičně podmíněná odolnost hostitele. Jedná se o dva patogenní komplexy: skupinu původců listových skvrnitostí a komplex chorob pat stébel, v rámci kterých je důležité citlivost k fungicidům sledovat. Pozornost zaměřujeme především na široce používané fungicidní látky, u nichž již byla rezistence prokázána v zahraničí a existuje předpoklad jejího rozšíření i v ČR.
Vývoj fungicidní rezistence
V období počínaje sedmdesátými léty minulého století doznala chemická pesticidní ochrana mimořádného rozvoje. Pro každou dekádu byly typické novinky mezi účinnými látkami, které rozvoj používání tehdy nové chemické skupiny rozvinuly.
Od uvedeného období až po současnost jsou triazoly ze skupiny inhibitorů syntézy sterolu nejrozsáhlejší, a také stále klíčovou chemickou skupinou fungicidů. Rezistence různé úrovně již byla prokázána u celé řady patogenů a obvykle se riziko vzniku rezistence vůči této skupině látek hodnotí jako střední. Důvodem jejich dlouhé doby používání je fakt, že nepatrné snížení citlivosti patogenů bylo vždy navráceno do více méně výchozí pozice zavedením další aktivní molekuly na trh. Tato až výjimečná dlouhodobost se však zdá být u řady látek ze skupiny triazolů u konce a to ne z důvodů horší účinnosti, ale především zpřísněním ekotoxikologických parametrů používání.
Pro efektivní ochranu proti komplexu chorob pat stébel je dlouhodobě významné používání účinné látky prochloraz. Ta byla jako součást podskupiny imidazolů z výše uvedené skupiny inhibitorů syntézy sterolu zavedena do praxe v roce 1977. Rezistence hub vůči látkám z této skupiny se obvykle vyznačuje polygenním charakterem, tedy mutací bývá několik s nižším faktorem rezistence. Obvykle nedochází k celkovému rychlému selhání rezistence, spíše se jedná o postupné snižování účinnosti. Jedinci s mutantními alelami mají nižší fitness a po ukončení používání látek této skupiny se populace vrací do původního stavu, tedy převládnou jedinci citliví k inhibitorům sterolu.
Druhou nejrozsáhlejší skupinou syntetických fungicidů jsou strobiluriny zavedené na trh v roce 1996. Jejich předností a důvodem široké obliby používání byla především vysoká účinnost a použitelnost u řady různých plodin. Strobiluriny představovaly rovněž nový způsob účinku oproti předešlým fungicidním skupinám - narušení procesu dýchání zamezením přenosu elektronů po membráně mitochondrií. Široké používání strobilurinů i v jednosložkově formulovaných přípravcích vedlo v průběhu času ke vzniku rezistence u celé řady houbových organizmů. Jedinci s mutantní alelou genu pro cytochrom b (nejčastěji mutace v kodonu 143) vykazují vysoký faktor rezistence. Rezistence vůči látkám s této skupiny vzniká velmi rychle v řádu několika málo let a riziko vzniku rezistence je tedy hodnoceno jako velmi vysoké. Na rozdíl od předchozí skupiny, mutace v genu pro cytochrom b nesnižují fitness svého nositele, a taková rezistence poté přetrvává v populaci velmi dlouho i po přerušení používání strobilurinů v ochraně rostlin.
Dýchací řetězec hub narušují i látky z další skupiny a to tzv. inhibitory syntézy sukcinát dehydrogenázy (SDHI). Ve druhém desetiletí tohoto století se staly alternativou narůstajících problémů s rezistencí patogenů vůči strobilurinům, které ovlivňovaly mimo jiné i obchod s přípravky (například rozsáhlá necitlivost na fungicidní zákroky původce septoriové skvrnitosti pšenice - Zymoseptoria tritici v západní Evropě). Jedná se o rozsáhlou skupinu látek, navazujících na účinnou látku carboxin, zavedenou na trh již v roce 1966, známou díky vysoké účinnosti proti snětím a svým využitím v mořidlech. Rezistence opět vzniká mutacemi genu pro sukcinát dehydrogenázu, přičemž různé mutace zapříčiňují různou úroveň faktoru rezistence. Riziko vzniku rezistence vůči SDHI je hodnoceno jako střední až vysoké. Všechny komerčně rozšířené účinné látky této skupiny se napojují do respiračního řetězce patogenů ve stejném vazebním místě a tudíž existuje předpoklad „cross rezistence“ (snížená citlivost k jedné z účinných látek se vztahuje i na další účinné látky ze stejné skupiny).
Obecně nejvyšší riziko vzniku rezistence je u plodin, které vyžadují opakovaná ošetření během sezony jako například u ovocných kultur nebo vinné révy. U obilnin je riziko sice nižší, ale původci padlí obilnin či tmavohnědé skvrnitosti ječmene (Ramularia collo-cygni) patří mezi patogeny s vysokým rizikem vzniku rezistence. Právě na příkladu padlí pšenice a ječmene je možné dokumentovat již dříve zmíněný fakt, že jedním z významných faktorů ochrany proti chorobám je účinná geneticky podmíněná odolnost (dlouhodobá efektivita genu odolnosti mlo u jarních ječmenů). Další druhy patogenů jako Oculimacula spp., Microdochium spp., Zymoseptoria tritici a Pyrenophora teres patří mezi houby se středním rizikem vzniku rezistence k fungicidům.
Monitoring rezistence
Na území České republiky bylo v letech 2015–2018 z provozních ploch nasbíráno celkově více než 600 izolátů následujících původců chorob obilnin: Microdochium spp., Oculimacula spp., Zymoseptoria tritici a Pyrenophora teres.
Jednotlivé izoláty byly získány z rostlinného materiálu (bazálních částí rostlin a listů pšenice a ječmene s příznaky chorob). Například u sledování septoriové skvrnitosti pšenice byl rostlinný materiál odebírán v době jarní regenerace, kdy se porosty ozimé pšenice nacházely ve stadiu plného odnožování. Přibližně ve stejné době se provádí i vyhledávání výskytu původce stéblolamu a plísně sněžné na bázích odnožujících rostlin.
Jednotlivé listy s příznaky choroby (léze s pyknidami), byly umístěny na vlhký filtrační papír a inkubovány při pokojové teplotě 24 hodin. Pyknidy uvolní cirry s pyknosporami. Tyto v rámci jedné pyknidy vznikají nepohlavním množení a jsou geneticky jednotné. Sterilní jehlou byl přenesen takto uvolněný obsah jednotlivých pyknid na samostatné Petriho misky s bramborovo-dextrozovým agarem (PDA) a inkubován při 20 °C 5 dní ve tmě. Následně byly vyříznuty disky mycelia o průměru 1,5 mm a přeneseny na bramborový agar, do kterého byl přidán streptomycin a testovaný fungicid.
Vlastní test byl proveden in vitro na Petriho miskách s bramborovo-dextrozovým agarem a odstupňovanými dávkami fungicidních látek 0,0; 0,01; 0,1; 1,0 a 10.0 μg/ml. Byl měřen průměr kolonií a pomocí probitové analýzy vypočtena koncentrace ED50.
Byly testovány následující fungicidní látky - DMI: prochloraz (Oculimacula spp., Microdochium spp.), látky ze skupiny Qol: azoxystrobin a SDHI: penthiopyrad (Zymoseptoria tritici a Pyrenophora teres).
Graf 1: Posun v zastoupení rezistentních jedinců (červeně) v populaci Zymoseptoria tritici na území ČR
Výsledky monitoringu
Byly prokázány výskyty snížené citlivosti k fungicidům a jejich plošná lokalizace, a to především u populací Pyrenophora teres a Zymoseptoria tritici.
Během posledních pěti let došlo k výraznému navýšení rezistentních izolátů Zymoseptoria tritici v populaci. Zatímco v roce 2015 byla zhruba polovina analyzovaných jedinců rezistentní vůči strobilurinům, v roce 2018 již byla populace ze sta procent plně rezistentní (graf 1, mapa 1).
Mírný nárůst jedinců s rezistencí vůči strobilurinům byl pozorován i u houbového patogenu ječmene Pyrenophora teres. Zatímco v roce 2015 byla rezistentní zhruba čtvrtina populace, v loňském roce to bylo téměř 50 % jedinců (mapa 2).
Velmi zajímavým zjištěním je záchyt prvních izolátů P. teres s rezistencí vůči látce ze skupiny SDHI (mapa 3). Zatímco na západ od našich hranic jsou jedinci s rezistencí avizováni již několik let, u nás se podle našich informací dosud nevyskytovali. Tuto situaci bude nutno bedlivě sledovat.
Zvýšená míra rezistence některých jedinců Oculimacula spp. (původce stéblolamu) je sledována na území ČR pravidelně již několik let, avšak nejedná se o zvyšující se trend spíše o sporadické nálezy (obr. 5). Je to zajímavé zjištění, zejména v kontextu poměrně rozšířené rezistence stéblolamu vůči prochlorazu zejména ve Francii. I tento vývoj je nezbytné pozorně sledovat a v případě posunu směrem k rezistenci na situaci rychle reagovat.

Mapa 1: Výskyt rezistentní reakce Zymoseptoria tritici vůči strobilurinům v letech 2015–2018 na našem území

Mapa 2: Výskyt rezistentní reakce Pyrenophora teres vůči strobilurinům v letech 2015–2018 na našem území

Mapa 3: Výskyt rezistentní reakce Pyrenophora teres vůči SDHI v roce 2018 na našem území

Mapa 4: Výskyt rezistentní reakce Oculimacula spp. vůči prochlorazu v letech 2015–2018 na našem území
Závěr
V našich testech jsme zjistili, že například v dílčích populacích původce septoriové skvrnitosti pšenice, síťovité a tmavohnědé skvrnitosti ječmene došlo na území ČR k obecnému snížení citlivosti k QoI fungicidům.
Výrazně se zvýšil podíl rezistentních izolátů, který v roce 2015 dosahoval u Zymoseptoria tritici téměř poloviny testovaného souboru, pak již v roce 2018 dosáhl 100 % rezistentních jedinců.
Nových účinných látek, které by pomohly situaci řešit, není mnoho, objevují se pouze sporadicky nové látky s novým mechanizmem účinku, takže je nutno spolehnout se na dosud ověřené strategie oddálení masivního rozvoje rezistence v populacích. Proto lze doporučit kombinované fungicidy, obsahující více účinných látek s různým mechanizmem účinku a střídat jednopolohové fungicidy s vícepolohovými. Tomu by měl předcházet celý soubor agronomických zásahů, od výběru odrůd, technologie zpracování půdy až po osevní sled.
Vzhledem k tomu, že jak septoriová skvrnitost pšenice, tak i síťovitá skvrnitost ječmene jsou chorobami velmi destruktivními s výrazným vlivem na výnos ozimé pšenice a jarního ječmene, je v širokém zájmu nejen spotřebitelů ale i výrobců a distributorů pesticidů sledovat účinnost všech uvedených možností k tomu, abychom oddálili či zamezili další rozšíření rezistence. Pro české a moravské agronomy je důležité vědět, které patogenní organizmy ohrožují jejich porosty a jak proti nim co nejúčinněji zasáhnout. Škála fungicidních přípravků je značně rozmanitá a není jednoduché se správně orientovat třeba jen v optimálních termínech použití. Některé a to především moderní a širokospektrální účinné látky vyžadují striktně dodržovat preventivní aplikační termín, kdy struktury patogenu nejsou v rostlinných pletivech ještě zformované.
Pokud budeme hledat v dostupných zdrojích informace o problematice aktuálního stavu rezistence houbových patogenů obilnin vůči fungicidům, nejčastěji se nám podaří najít údaje zahraniční. Nadnárodní organizace výrobců pesticidů koordinují sledování stavu a změn citlivosti k přípravkům a výrobci vynakládají na tuto činnost nemalé finanční prostředky. Jedná se přece o možné výpadky v prodejích v rámci velkých území, tedy o ohrožení ekonomických zájmů. Česká republika svou velikostí, ale i geografickou polohou není pro tyto studie klíčová a tomu odpovídá často i menší rozsah monitorovaných případů.
Tato skutečnost byla jedním z významných důvodů, proč jsme se před několika lety připojili ke Zkušební stanici Kluky spol. s r. o. a začali v oblasti Moravy provádět pravidelné sledování porostů polních plodin. Získaný biologický materiál, tedy izolované kmeny patogenů tvoří základ naší kolekce, využívané k takovým studiím, jaké jsme čtenářům v tomto příspěvku představili. A jsme rádi, že se podařilo část zjištění využít k naplnění části cílů výzkumného projektu Národní agentury pro zemědělský výzkum, zaměřeného na rozvoj systémů integrované ochrany rostlin. Poděkování patří rovněž společnosti Dow Agrosciences, která v posledních letech významně podpořila plošné studie rezistencí vůči fungicidům.

Septoriová skvrnitost listů pšenice
Zymoseptoria tritici (izoláty na Petriho miskách), původce septoriové skvrnitosti listů pšenice
Microdochium spp. (izoláty na Petriho miskách), původce sněžné plísňovitosti obilnin
Oculimacula spp. (původce stéblolamu) a Microdochium spp. (původce sněžné plísňovitosti) na Petriho misce
Dr. Ing. Ludvík Tvarůžek, Mgr. Ivana Svačinová, Ing. Simona Růžková, Mgr. Pavel Matušinsky, Ph.D., Mgr. Dominik Bleša, Ing. Markéta Hambálková; Agrotest fyto, s.r.o., Kroměříž
Další články v kategorii Choroby











RSS
RSS